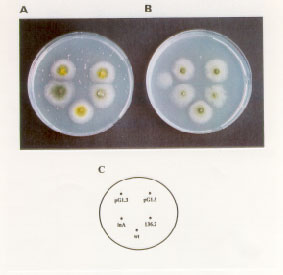

An alternative strategy for cloning minor permeases in Aspergillus nidulans
L. Harispe#, P. Tucci#, C. Portela and L. Gorfinkiel*-
Sección Bioquímica, Facultad de Ciencias, Iguá 4225,
Montevideo, Uruguay. * Corresponding Author # Both authors contributed
equally to this work.
FGN 47:61-64
The uapC gene was cloned by complementation of the cryosensitive phenotype of uapA mutants following the "instant gene bank" method. The analysis of the transformants is presented and a strategy to clone other transport related genes is proposed.
In order to identify genes whose products could complement the cryosensitivity of uapA mutants we made use of the "instant gene bank" method for gene cloning by mutant complementation in Aspergillus nidulans. This method uses ligation in vivo of donor DNA and an autonomously replicating plasmid (Gems et al., 1994 Mol. Gen. Genet. 242:467-471). A strain carrying a deletion of the uapA gene --uapA-- and the mutation argB2 is unable to grow on UA or xanthine as sole nitrogen source at 25°C and is auxotrophic for arginine. This strain was transformed with total genomic DNA isolated from the uapA strain, purified by CsCl density gradient ultracentrifugation and partially digested by Sau3A restriction enzyme to obtain an average fragment length of 4-6 kb. The cloning vector pDHG25 (construction described in Gems et al., 1991 Gene 98: 61-67), contained the AMA1 element, promoting autonomous replication in Aspergillus, and the argB gene for initial selection of transformants. The vector was made linear at its unique BamHI site. Three micrograms of the vector was mixed with 10 µg of the donor DNA and used in transformation of about 5 X 107 protoplasts of A. nidulans strain argB2 uapA. The transformation mixtures were plated in standard Petri dishes with osmotically buffered protoplast regeneration minimal medium supplemented with UA and incubated at 25°C. Ten thousand uapAargB+ transformants were scored and one colony growing on the selective agar plates at the restrictive temperature was obtained after 5 days of incubation. The purified transformant grew on minimal medium containing UA as sole nitrogen source better than the recipient strain and showed an irregular growth phenotype (Fig. 1). Plasmid rescue in E. coli was performed as described previously. Twenty ampicillin resistant colonies were tested and all of them contained the same plasmid of 21-22 Kb, pG1. This plasmid is capable of re-transforming the uapAargB2 strain to arginine prototrophy/growth in UA at 25°C at an efficiency of 30 colonies per µg of DNA. These "second generation" transformants grew better than the initial one in plates with UA and were more sensitive to the effect of 2-TX. (Fig. 1)
The stability of the transformants was examined by plating conidia on non-selective medium and subsequent replica plating onto arginine-free minimal media with UA as sole nitrogen source at the restrictive temperature. The original transformant showed a 17% of mitotic instability while the second generation transformants lost their plasmid in 55-60% of the asexual progeny.
The rescued plasmid contained the uapC gene as evidenced by its restriction pattern enzyme analysis (Fig. 2). Strongest evidence was provided by PCR amplifications. The rescued plasmid and a plasmid containing the previously cloned gene were amplified by PCR with two different pairs of uapC specific oligonucleotides. The same band is amplified in both plasmids (Fig. 3). Moreover, the PCR products obtained with oligos 10 and 12 (Fig. 3, lanes 3 and 4) were precipitated and cut with Ava I restriction enzyme. The expected fragments of 490 and 101 bp were obtained, showing the identity of the amplified DNA and the uapC sequence. The PCR products obtained with oligos 17 and 20 (Fig. 3, lanes 8 and 9) were precipitated and digested with Hpa I. The expected fragments of 318 and 293 bp were obtained showing again the identity of the rescued plasmid insert and the uapC gene (Fig. 4).
This gene had already been cloned by heterologous hybridization with a uapA specific probe. It codes for a broad specificity, low affinity permease able to incorporate all natural purines and their thioanalogues in the cell (Diallinas et al., 1995 J.Biol.Chem. 270:8610-8622).
Southern blot analysis of genomic digested and undigested DNA from the original and secondary transformants (not shown) suggested the prescence of multiple copies of the cloned gene in the latters.
This strongly suggests that while a single copy of the uapC gene (the resident endogenous copy) does not allow grow of a uapA deleted strain on UA as sole nitrogen source at 25°C, multiple copies do. Alternatively, as already described, an ectopic integration of uapC gene may lead to a non cryosensitive transport activity.
The results presented here describe the cloning of the uapC gene by complementation of a cryosensitive phenotype. Both the recipient strain and the donor DNA were wild type for this gene. The methodology employed can be used to clone other minor permeases or transport related genes for which there is no mutant known. To avoid the cloning of uapC, the donor strain should therefore contain a deletion of this gene.
The UapC residual activity is not detected under a given assay condition whereas the presence of multiple copies of the gene responsible for it bypass the restrictive condition. Any gene responsible for a residual activity, not detected under a given condition (low temperature in this case) can be cloned in this way provided the presence of multiple copies of the gene responsible for it bypass the restrictive condition.
Moreover, this procedure can be extended to other pathways or functions to clone genes responsible for residual activities detected only upon the complete loss of function mutations in the main gene.
This work was partially supported by IFS.
Figure 1. Growth tests of the transformants. Growth was monitored on appropriately supplemented minimal medium with 1% (w/v) D-glucose as carbon source and A) 3.3 mM of ammonium (as the (+)-tartrate) as nitrogen source in presence of 0.1 mg/ml of 2-thioxanthine and B) 0.1 mg/ml of uric acid as nitrogen source after 5 days at 25°C. C) Strains: wt: wild type for purine permeases, inA: uapA inactivated, 136.2: original transformant, pG1.3 and pG1.5: second generation transformants (uapAargB2 strain transformed with pG1).
Figure 2: XhoI (lanes 1,2) and PstI (lanes 3, 4) digestions of pG1(lanes 1 and 3) and pAN903 (a plasmid containing the uapC gene cloned, lanes 2 and 4). The 1.5 and 1.6 kb bands of the PstI digestion (black arrow), and the 0.9 kb band of the XhoI digestion (hatched arrow) are characteristic of the restriction enzyme pattern of the DNA sequence of the uapC gene.
Figure 3: Products of PCR amplifications performed with uapC specific oligonucleotides. Lanes 1 to 4: oligo 10 (5' ATTCAGGGTGGCGTCC 3') and 12 (5' GACCAGAGGAACCAGGC 3') were used. Lanes 6 to 9: oligo 17 (5' GGCAACGCAATGAAAGAC 3') and 20 (5' CCATTACAACGAGGAAGAAGC 3') were used. Lanes 1 and 6: no DNA was added to the reaction, lanes 2 and 7: pDHG25 was used as DNA template, lanes 3 and 8: pAN903 -the plasmid containing the previously cloned gene- was used as DNA template, lanes 4 and 9: pG1 -the rescued plasmid- was used as DNA template. About 10 ng of each plasmid were amplified by 35 cycles under the following conditions: denaturation for 1 min at 94°C, annealing for 1 min at 56°C and elongation for 1 min at 74°C using the Taq polymerase (Boehringer, Mannheim). The expected products of 591bp (oligos 10 and 12) and 611 bp (oligos 17 and 20) were obtained and run in a 1.5% agarose gel. Lane 5: PCR markers (Promega) was used, sizes of the fragments: 50, 150, 300, 500, 750 and 1000 bp. The uapC sequence had been previously submitted to the GenBank with accesssion number X79796.
Figure 4: Restriction enzyme digestion of the PCR products. Lanes 2 and 3: Hpa I digestion of the 611 bp DNA fragment amplified with oligos 17 and 20. The expected fragments of 318 and 293 bp are obtained. Lanes 5 and 6: Ava I digestion of the 591 bp DNA fragment amplified with oligos 10 and 12. The expected fragments of 490 and 101 pb can be observed. Lanes 1 and 4: PCR marker.
Return to the FGN 47 page
Return to the main FGN page
Return to the FGSC main page
Last modified 8/3/00 KMC